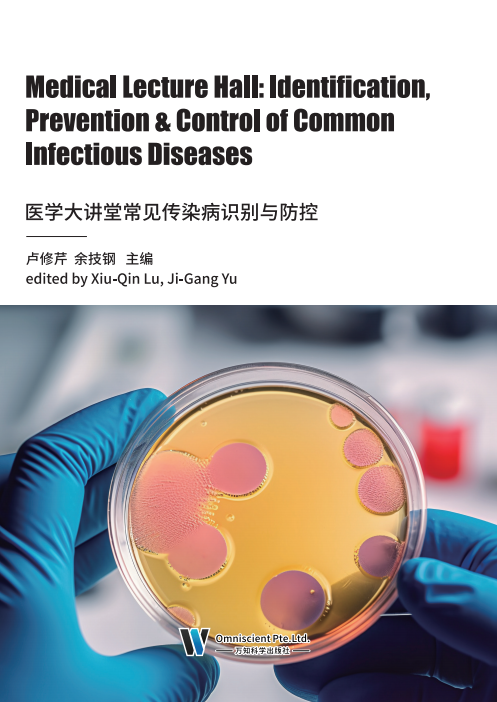

电力是现代社会的基础,它驱动着工业、商业和家庭中的各种设备,照亮我们 的环境,让我们的电子设备得以运行。随着社会的发展和科技的进步,电力需求持续增长,电力工程的规模也在不断扩大。然而,随着电力工程的复杂性和规模的增大,电力工程的技术创新与安全防护管理也变得越来越重要。电力工程技术创新的 理论与方法是推动电力工程发展的重要支撑。这涉及创新理论体系的建立,创新思维方式的培育,创新管理模式的探索,以及创新风险的控制等多个方面。此外,知识产权保护和运用,以及国际合作与交流也是推动电力工程技术创新的重要途径。 此外,本书还介绍了电力安全生产常识、安全技术和职业健康安全管理等方面的内 容。本书旨在为从事电力工程的技术人员和管理人员提供全面的理论和实践指导, 同时也为相关领域的研究人员提供了有价值的参考。通过深入了解电力工程的技术 创新和安全防护管理,我们可以更好地推动电力工程的发展,满足社会的需求,保障电力系统的安全稳定运行。

林业既是一项十分重要的公益事业,又是一项十分重要的民生产业,林业是实现 绿色经济的基础和关键。一是林业是绿色经济的重要生态基础。林业承担着保护和建 设森林生态系统、保护和恢复湿地生态系统、治理和修复荒漠生态系统、维护和发展 生物多样性的重要职责。林业在实现绿色转型国家战略中发挥着重要作用,特别是林 业对生态安全、粮油安全、资源安全、气候安全、淡水安全贡献突出,将对实现可持 续发展和千年发展目标做出重要贡献。二是林业在增加就业和减轻贫困中发挥着重要 作用。 林业是绿色经济发展的生态资本。生态系统管理在绿色经济发展中发挥着重要作 用。森林是重要而独特的战略资源和能源,具有可再生性、多样性、多功能性,是发 展绿色经济十分重要的自然资产。许多林业产业本身就是绿色产业。林业为绿色经济 的发展创造了绿色财富,对绿色经济的物质基础提供了强大保障。 本书是一本关于林业绿色经济理论与实践研究的书籍,旨在为相关工作者提供有 益的参考和启示,适合对此感兴趣的读者阅读。本书详细介绍了绿色经济理论概述, 让读者对绿色经济有初步的认知;深入分析了林业与绿色经济、林业与生态文明建 设、新兴林业绿色经济产业等内容,让读者对林业绿色经济有更深入的了解;着重强 调了林业绿色管理与绿色制度,以理论与实践相结合的方式呈现。林业是绿色经济的 重要部门,林业经济是绿色经济的重要构成和核心体现。林业绿色经济发展的重要意 义不言而喻。本书论述严谨,结构合理,条理清晰,内容丰富新颖,具有前瞻性,可 作为林业领域和绿色经济领域的专家学者的参考读物。本书在写作的过程中参考了大 量的文献资料,不能一一列出,在此向参考文献的作者表示崇高的敬意。由于水平有 限,书中难免存在很多不足之处,恳请各位专家和读者,能够提出宝贵意见,以便进 一步改正,使之更加完善。

风景园林是典型的综合性学科,其中的园林绿化养护管理工作基于前期规划设计 和施工基础上开展,重要性不言而喻。需要从业者掌握的基础知识包括植物保护学、 园艺等农学,气象学、生态学等自然科学,植物学、生理学等生物科学,土壤学、植 物营养学等农业资源应用学,以及美学、社会学等多学科相关知识。同时要求从业者具备较好的实际运用能力,独立获取知识、信息处理和创新能力,一定的科学研究和实际工作能力,较强的综合分析、语言表达和解决实际问题能力等。园林绿化养护管理是一项长期艰巨的任务,随着经济社会的不断发展和人民生活水平的不断提高,生态文明建设的要求越来越高,园林绿化养护管理的高质量发展更加凸显。植物是风景园林以及环境艺术景观设计中最重要的素材之一,以植物材料为基础的景观设计必须 既讲究艺术性又讲究科学性。景观设计中的绿化不同于山石、水体、建筑景观的构 建,其区别于其他要素的根本特征是它的生命特征,这也是它的魅力所在。在实践 中,必须根据植物生物科学的基本理论,因地制宜,只有以植物的健康生长为基础,才能充分发挥其自然美的特性。 本书是园林绿化方向的书籍,主要研究园林绿化养护管理学与景观绿化设计,本书从园林绿化管理学基础理论入手,针对管理者、施工作业、责任管理作了简要说 明;还对园林树木、花卉与草坪栽种技术与养护管理进行了分析阐释,并着重探讨了园林生态管理与安全管理的相关内容;接着,本书在说明了园林景观艺术价值与规划 设计理论后,对园林绿地系统与植物选择、园林绿化组成要素的规划设计进行了深入 研究,最后结合城市道路、广场、居住区、公园等生活场景对植物景观设计的应用提 出了一些建议;对园林绿化养护管理与设计应用有一定的借鉴意义。
传染病是一种在人群中广泛传播的疾病,其发病率和死亡率较高,对人们的健康和生命构成严重威胁。为了提高人们对常见传染病的识别和防控能力,组织编写了本书,旨在介绍传染病的特征、流行过程、发病机制、预防、治疗、护理等方面的知识,帮助读者更好地了解和应对常见传染病。 本书共分为九章,包括传染病概论、传染病的诊断、传染病的治疗、医院内感染的预防和控制、传染病患者的护理、外科感染病人的护理、感染性疾病中成药临床应用、妇科细菌性感染疾病的识别与防控。本书在编写过程中,参考了大量的国内外相关文献和资料,结合临床实践经验,力求内容全面、实用、易懂。不仅适合广大医务工作者阅读,也适合普通读者了解和 学习常见传染病的识别和防控知识。希望通过本书,能够提高人们对常见传染病的认识和防控能力,为保障人类的健康和生命安全做出贡献。同时,也希望读者能够认真阅读本书,掌握相关知识,积极参与到传染病的防控工作中来。

安全生产是经济社会发展永恒的主题。只要人类从事生产经营活动,发展经济,一定会有人员伤害、死亡、设备损坏、爆炸等影响生产成果获得的事故或灾害发生。一句话,安全问题将伴随着生产经营活动的始终。我们从事安全生产工作,就是要防 范和遏制这些事故、灾害。材料、化工安全生产和环境保护是促进经济发展,构建和谐社会的重要保障: 是关系到广大员工生命财产和国家财产不受损失,保证国民经济可持续发展的重大问题。材料、化工生产具有易燃、易爆、有毒、有害、腐蚀性强等不安全因素,安全生产难度大。同时材料、化工生产工艺过程复杂、工艺条件要求苛刻,伴随产成品的生产会产生出各种形态不同的三废物质,对生态环境和生命环境具有极大的破坏作用。因此,我国一直高度重视安全生产和环境保护工作。本书是一本关于化工材料方向的著作,主要研究了化工材料生产安全及环保技术。本书首先从材料化工安全生产基础知识入手,针对化工防火防爆安全技术、工业防毒安全技术、化学反应过程安全技术、化工操作安全技术以及危险化学品的包装与运输安全等展开论述;其次阐述了电气安全、静电防护、防雷技术、化工设备安装及检修安全技术、化工装置运行安全技术等内容;最后介绍了环境管理的内涵,以及化工废气、废水、固体废弃物的污染与治理技术等。